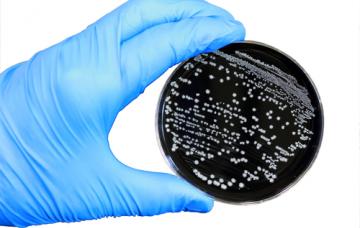
Diagnóstico de la infección por Campylobacter

Campylobacter

Especialista en Medicina Interna del Hospital Universitario Príncipe de Asturias
- 1

Qué es la infección por Campylobacter
La infección por Campylobacter es una de las causas más frecuentes de intoxicación alimentaria y cursa con diarrea. Conoce sus síntomas y cómo se transmite.
Leer más - 2

Síntomas del Campylobacter
Los síntomas de la infección por Campylobacter comienzan entre dos y cinco días tras el contacto con la bacteria, y pueden ser intestinales o de otro tipo.
Leer más - 3

Diagnóstico de la infección por Campylobacter
El diagnóstico de la infección por Campylobacter se basa en los síntomas y posibles alteraciones en la analítica, y se confirma mediante un coprocultivo.
Leer más - 4

Tratamiento de la infección por Campylobacter
El tratamiento de la infección por Campylobacter se basa en dieta astringente y reposición de líquidos, y los antibióticos solo se usan en caso necesario.
Leer más - 5

Prevención de la infección por Campylobacter
Para prevenir la infección por Campylobacter hay que cuidar la higiene alimentaria y del agua, lavarse bien las manos y desinfectar, entre otras medidas.
Leer más